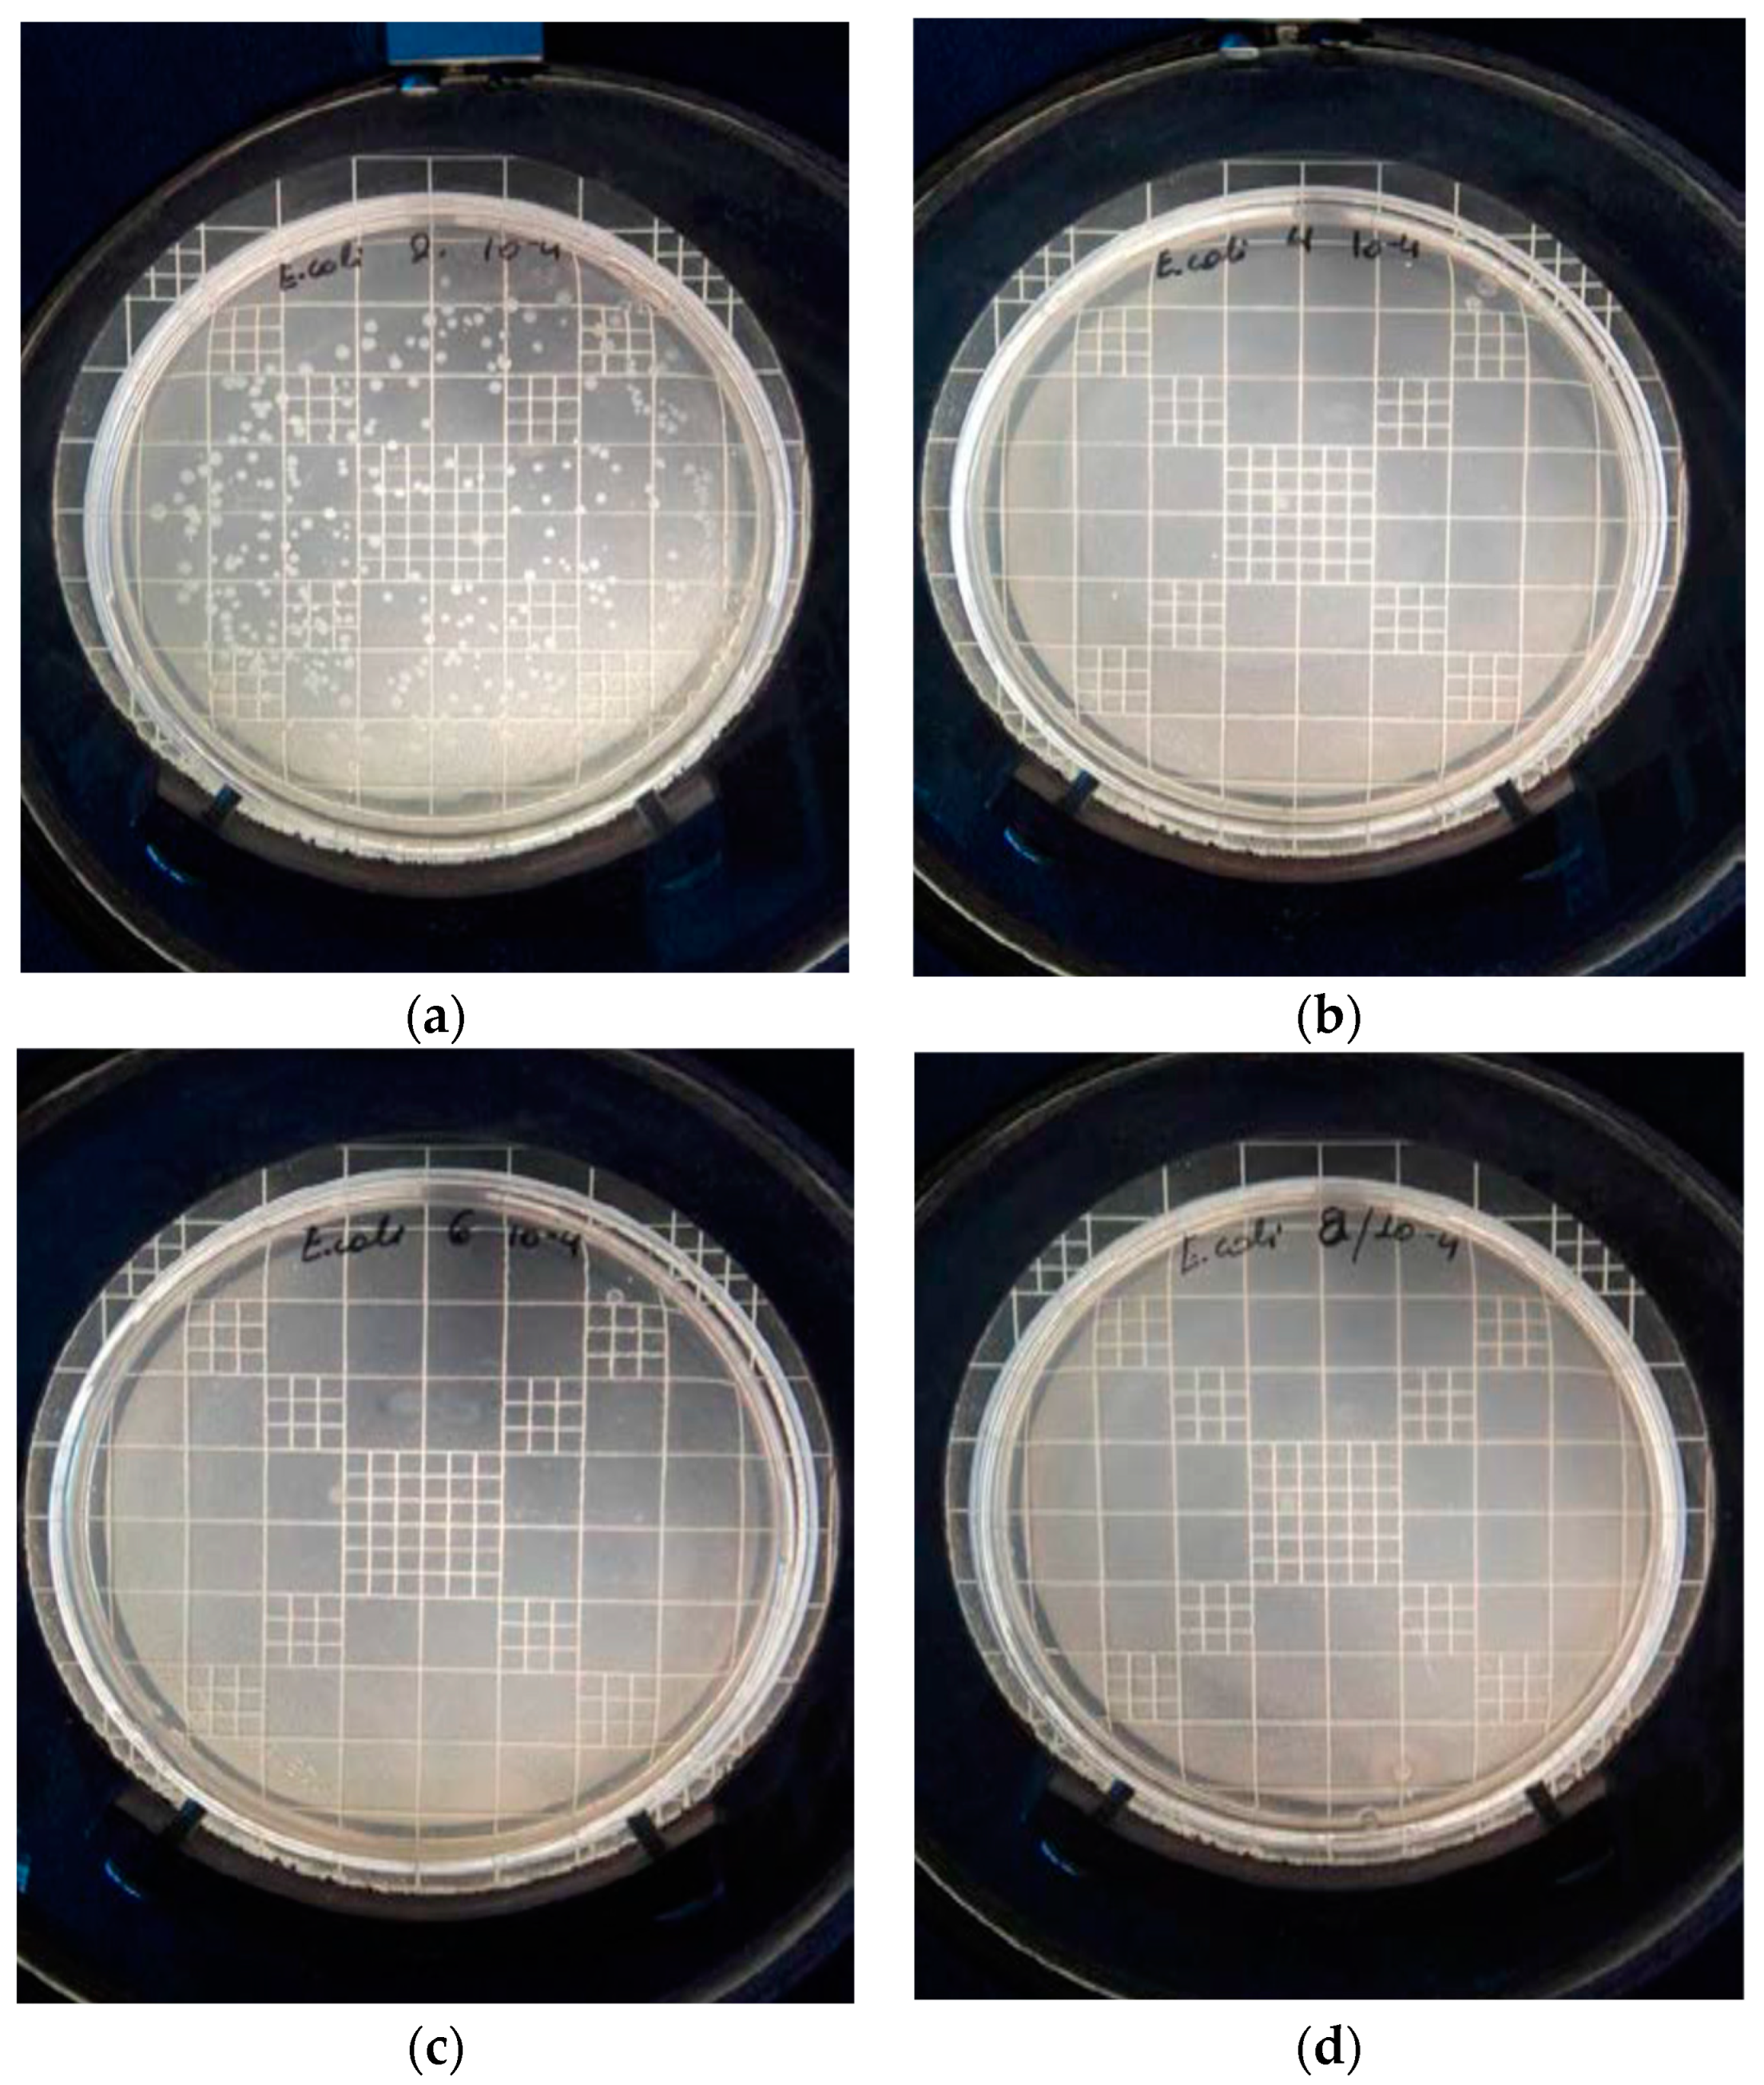
Nanomaterials 14 00291 g007
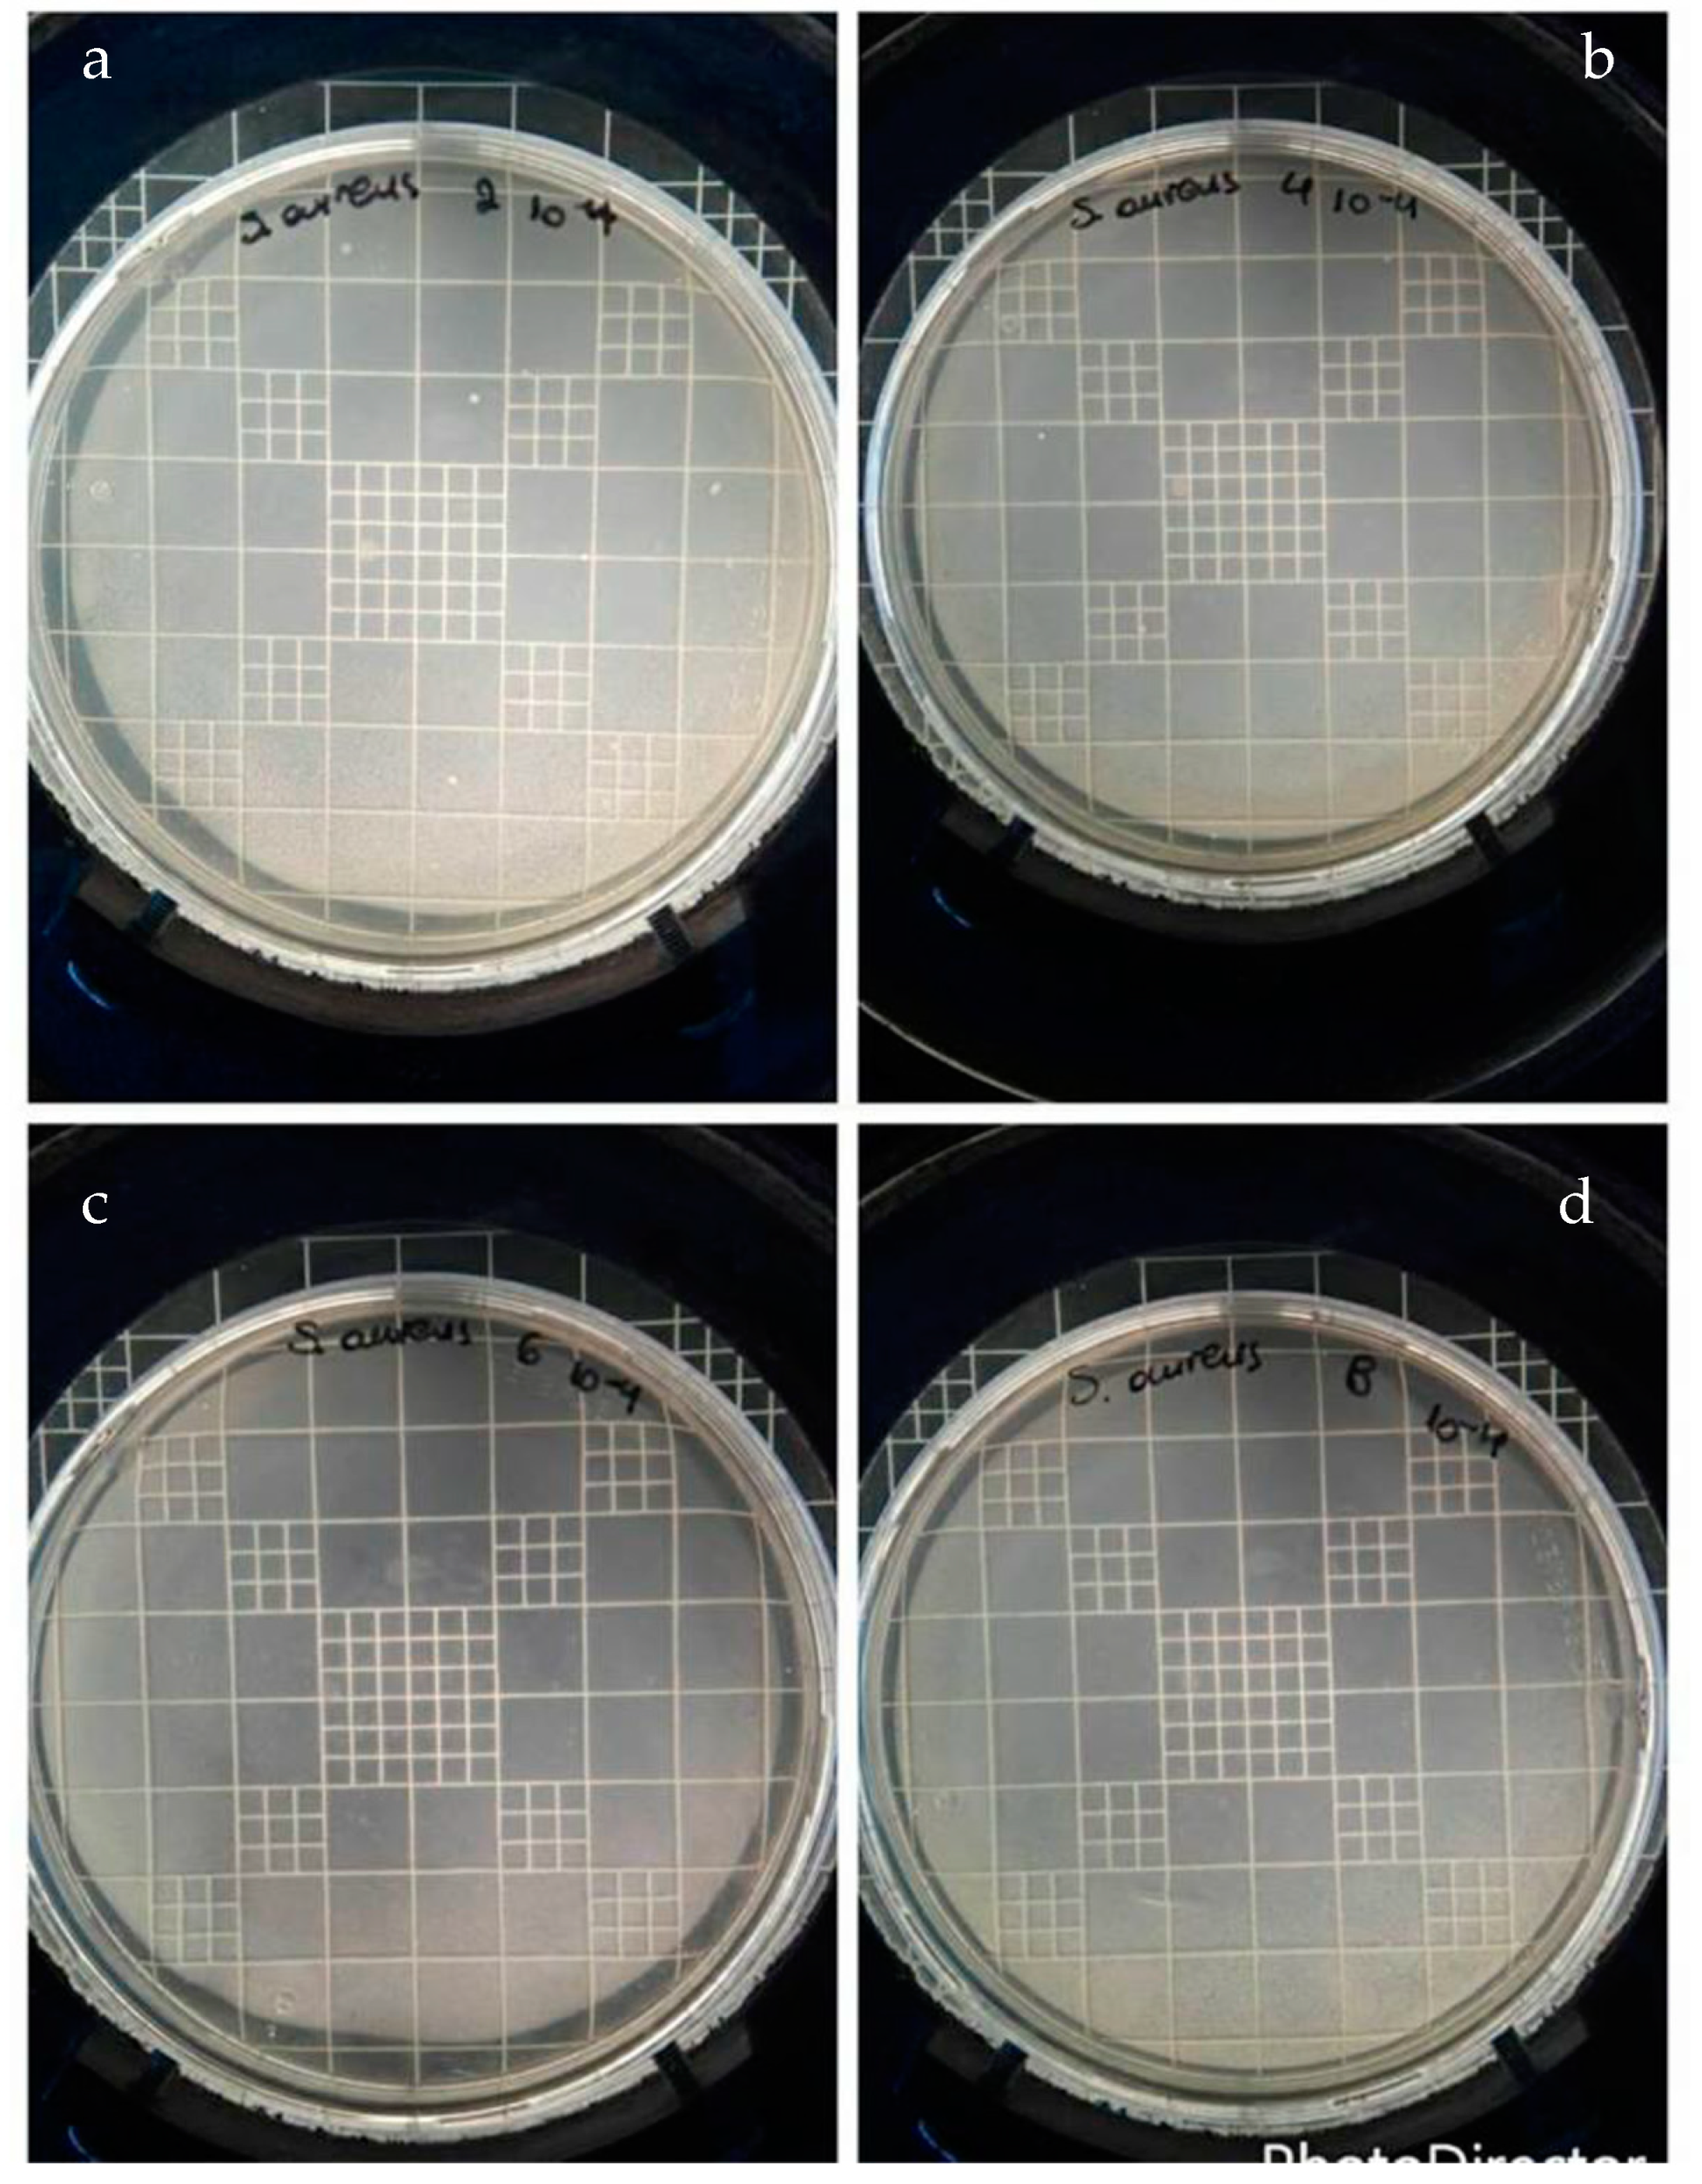
Nanomaterials 14 00291 g009
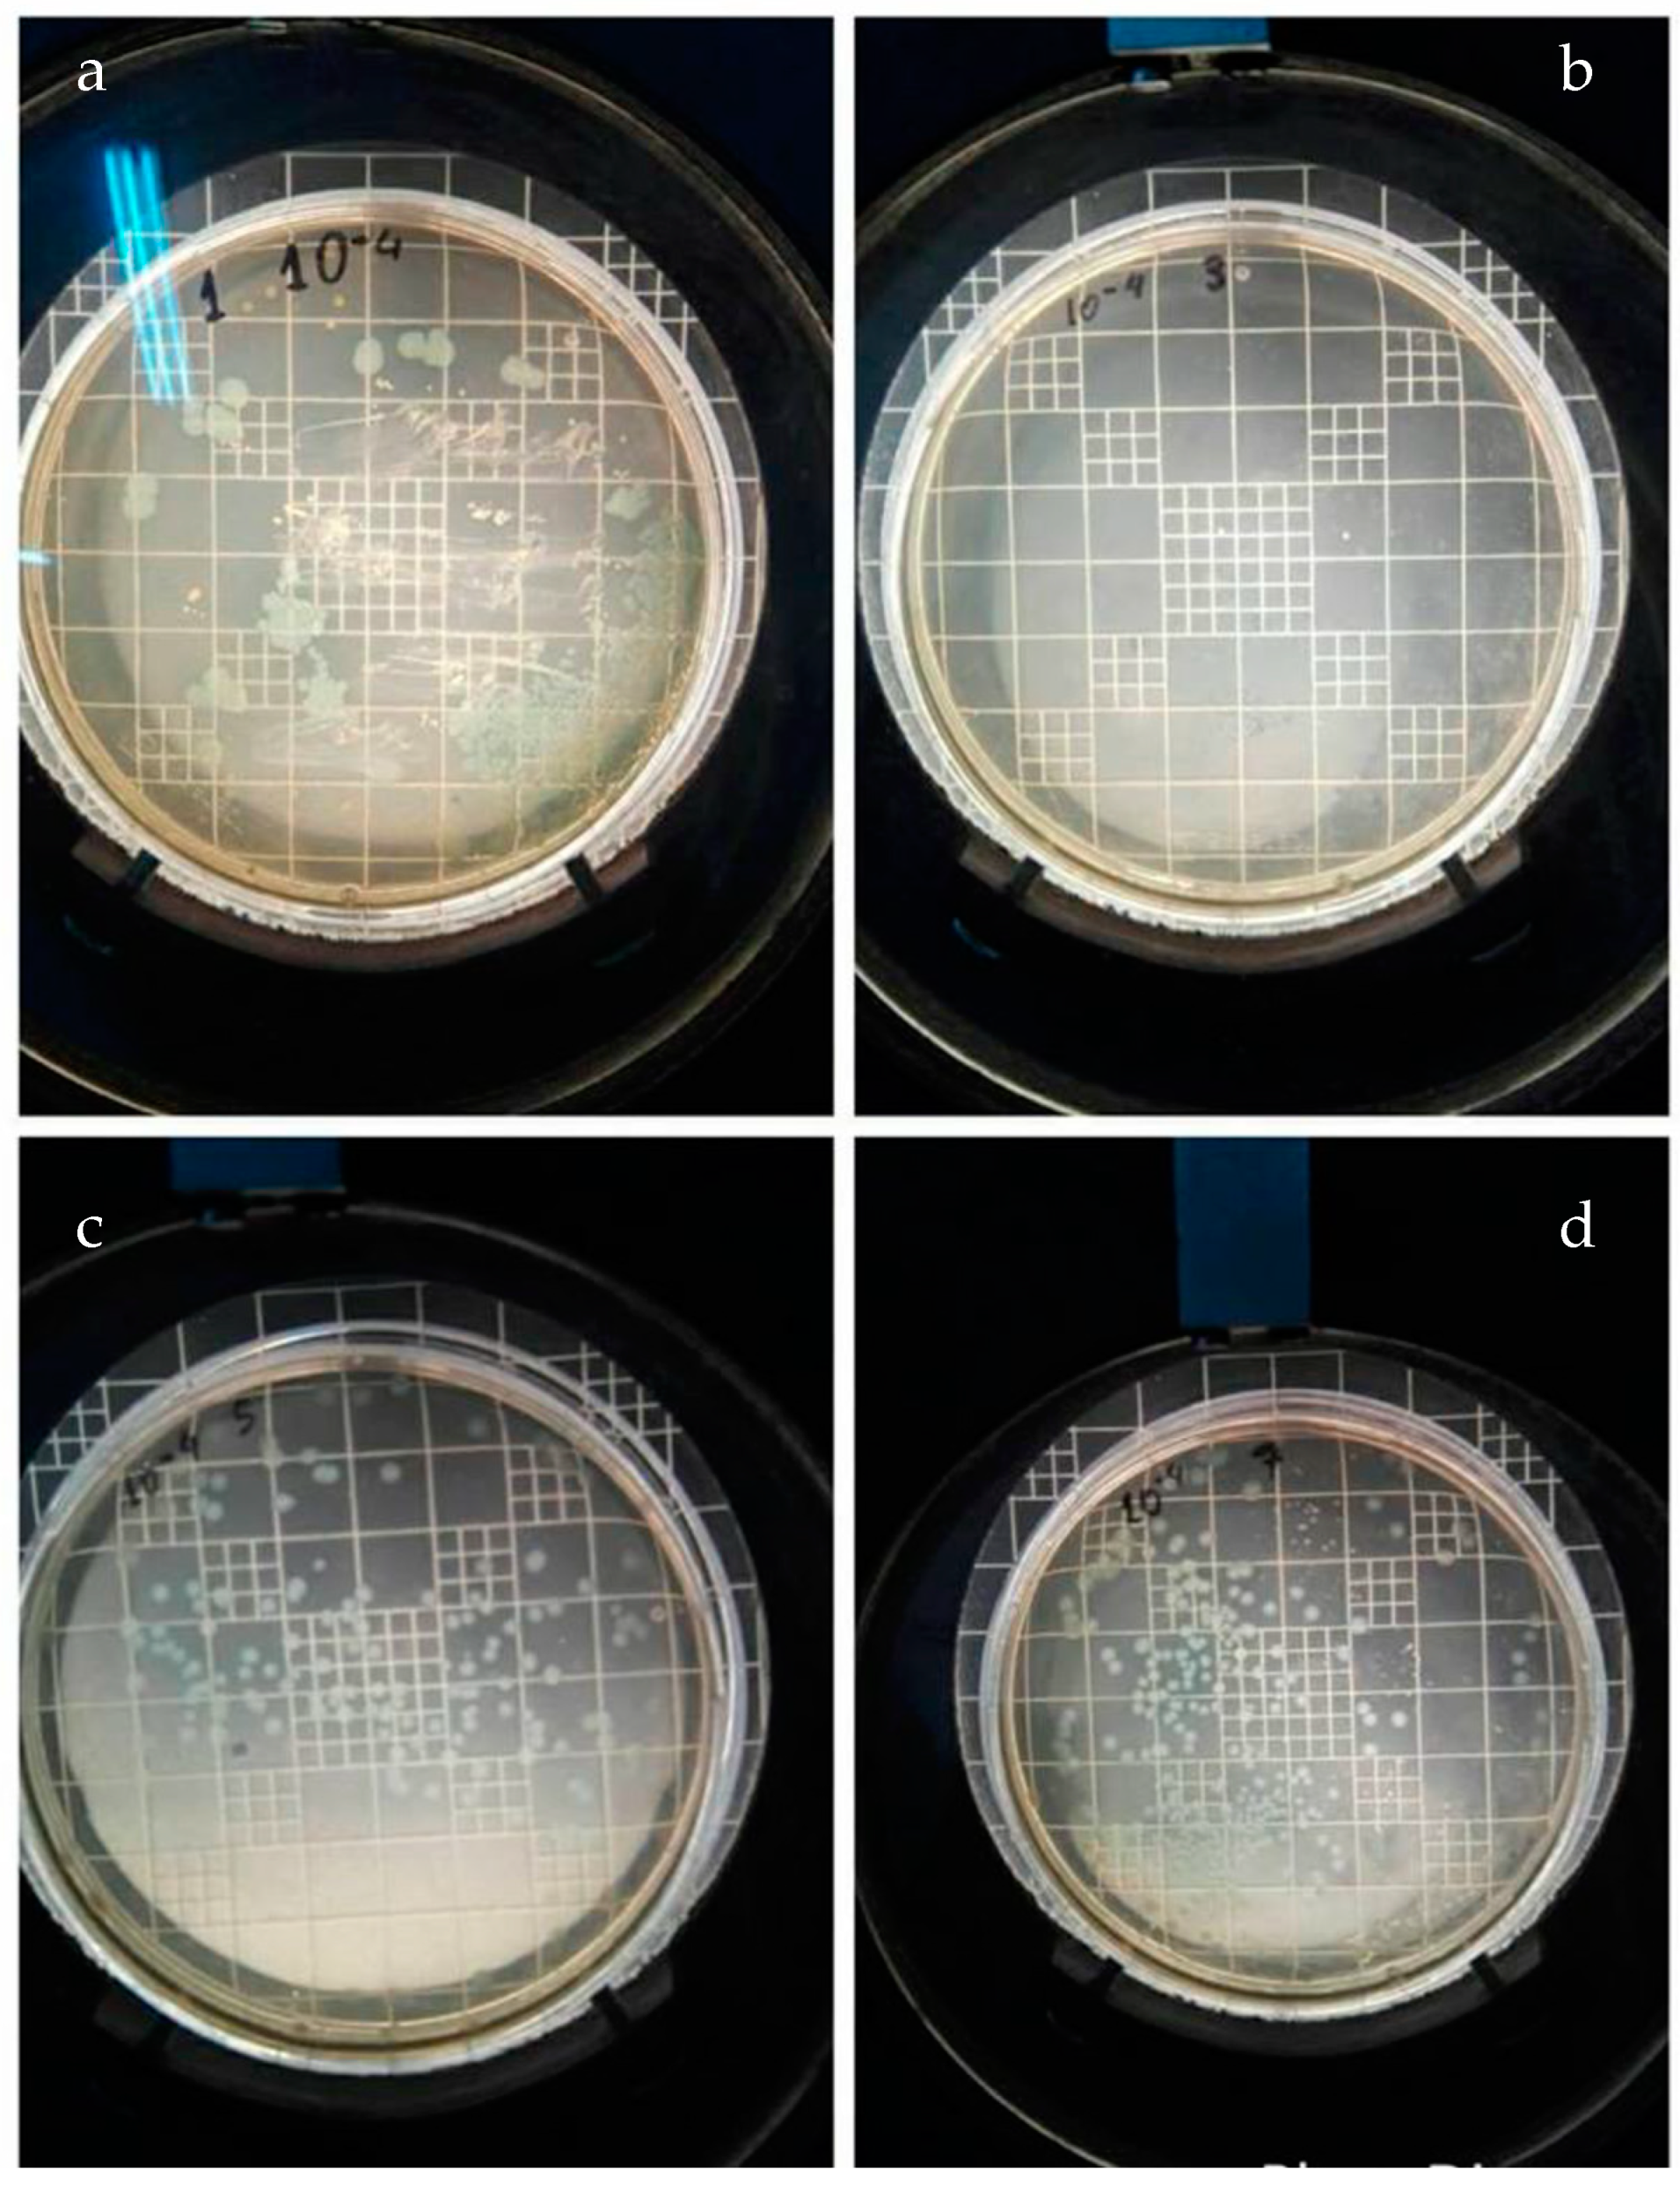
Nanomaterials 14 00291 g012

Synthesis of Novel Nanocomposite Materials with Enhanced Antimicrobial Activity based on Poly(Ethylene Glycol Methacrylate)s with Ag, TiO2 or ZnO Nanoparticles
Abstract
1. Introduction
2. Materials and Methods
2.1. Materials
2.2. Preparation of the Neat Polymers via Radical Polymerization
2.3. Preparation of the Nanocomposite Materials via In Situ Radical Polymerization
2.4. Analytical Techniques
2.5. Determination of Antimicrobial Properties
3. Results and Discussion
3.1. Characterization of the Samples
3.2. Thermal Stability of the Nanocomposites
3.3. Determination of In Vitro Antimicrobial Activity
3.3.1. Cultivation of E. coli on PEGMA and PEGMA/NPs
3.3.2. Cultivation of E. coli on PEGMEMA and PEGMEMA/NPs
3.3.3. Cultivation of Staphylococcus aureus on PEGMA and PEGMA/NPs
3.3.4. Cultivation of Staphylococcus Aureus on PEGMEMA and PEGMEMA/NPs
3.3.5. Cultivation of Bacillus subtilis on PEGMA and PEGMA/NPs
3.3.6. Cultivation of Bacillus subtilis on PEGMEMA and PEGMEMA/NPs
3.3.7. Cultivation of Baillus cereus on PEGMA and PEGMA/NPs
3.3.8. Cultivation of Bacillus cereus on PEGMEMA and PEGMEMA/NPs
3.3.9. Comparative Antimicrobial Results
4. Conclusions
Author Contributions
Funding
Data Availability Statement
Conflicts of Interest
References
- Vancoillie, G.; Frank, D.; Hoogenboom, R. Thermoresponsive poly(oligo ethylene glycol acrylates). Prog. Polym. Sci. 2014, 39, 1074–1095. [Google Scholar] [CrossRef]
- Lutz, J.-F. Polymerization of oligo(ethylene glycol) (meth)acrylates: Toward new generations of smart biocompatible materials. J. Polym. Sci. A Polym. Chem. 2008, 46, 3459–3470. [Google Scholar] [CrossRef]
- Lutz, J.-F.; Hoth, A. Preparation of Ideal PEG Analogues with a Tunable Thermosensitivity by Controlled Radical Copolymerization of 2-(2-Methoxyethoxy)ethyl Methacrylate and Oligo(ethylene glycol) Methacrylate. Macromolecules 2006, 39, 893–896. [Google Scholar] [CrossRef]
- Ishizone, T.; Seki, A.; Hagiwara, M.; Han, S.; Yokoyama, H.; Oyane, A.; Deffieux, A.; Carlotti, S. Anionic Polymerizations of Oligo(ethylene glycol) Alkyl Ether Methacrylates: Effect of Side Chain Length and ω-Alkyl Group of Side Chain on Cloud Point in Water. Macromolecules 2008, 41, 2963–2967. [Google Scholar] [CrossRef]
- Lutz, J.F.; Hoth, A.; Schade, K. Design of Oligo(ethylene glycol)-Based Thermoresponsive Polymers: An Optimization Study. Des. Monomers Polym. 2009, 12, 343–353. [Google Scholar] [CrossRef]
- Üzgün, S.; Akdemir, O.; Hasenpusch, G.; Maucksch, C.; Golas, M.M.; Sander, B.; Stark, H.; Imker, R.; Lutz, J.-F.; Rudolph, C. Characterization of Tailor-Made Copolymers of Oligo(ethylene glycol) Methyl Ether Methacrylate and N,N-Dimethylaminoethyl Methacrylate as Nonviral Gene Transfer Agents: Influence of Macromolecular Structure on Gene Vector Particle Properties and Transfection Efficiency. Biomacromolecules 2010, 11, 39–50. [Google Scholar] [CrossRef] [PubMed]
- Lutz, J.-F. Thermo-Switchable Materials Prepared Using the OEGMA-Platform. Adv. Mater. 2011, 23, 2237–2243. [Google Scholar] [CrossRef]
- Achilias, D.S.; Tsagkalias, I.S. Investigation of radical polymerization kinetics of poly(ethylene glycol) methacrylate hydrogels via DSC and mechanistic or isoconversional models. J. Therm. Anal. Calorim. 2018, 134, 1307–1315. [Google Scholar] [CrossRef]
- Buwalda, S.J.; Boere, K.W.; Dijkstra, P.J.; Feijen, J.; Vermonden, T.; Hennink, W.E. Hydrogels in a historical perspective: From simple networks to smart materials. J. Control Release 2014, 190, 254–273. [Google Scholar] [CrossRef] [PubMed]
- Ulaşan, M.; Çengeloğlu, Y.; Yavuz, M.S. Biocompatible Hydrogels: Synthesis, Swelling Property and Solvent Effect on Gelation. Selcuk. Univ. J. Eng. Sci. Technol. 2013, 1, 31. [Google Scholar]
- Caló, E.; Khutoryanskiy, V.V. Biomedical applications of hydrogels: A review of patents and commercial products. Eur. Polym. J. 2015, 65, 252–267. [Google Scholar] [CrossRef]
- Lee, B.S.; Chen, Y.J.; Wei, T.C.; Ma, T.L.; Chang, C.C. Comparison of Antibacterial Adhesion When Salivary Pellicle Is Coated on Both Poly(2-hydroxyethyl-methacrylate)- and Polyethylene-glycol-methacrylate-grafted, Poly(methyl methacrylate). Int. J. Mol. Sci. 2018, 19, 2764–2765. [Google Scholar] [CrossRef] [PubMed]
- Chang, T.; Gosain, P.; Stenzel, M.H.; Lord, M.S. Drug-loading of poly(ethylene glycol methyl ether methacrylate) (PEGMEMA)—Based micelles and mechanisms of uptake in colon carcinoma cells. Colloids Surf. B Biointerfaces 2016, 144, 257–264. [Google Scholar] [CrossRef]
- Giannelis, E.P. Polymer layered silicate nanocomposites. Adv. Mater. 1996, 8, 29–35. [Google Scholar] [CrossRef]
- Alexandre, M.; Dubois, P. Polymer-layered silicate nanocomposites: Preparation, properties and uses of a new class of materials. Mater. Sci. Eng. R Rep. 2000, 28, 1–63. [Google Scholar] [CrossRef]
- Tsagkalias, I.S.; Manios, T.K.; Achilias, D.S. Effect of graphene oxide on the reaction kinetics of methyl methacrylate in situ radical polymerization via the bulk or solution technique. Polymers 2017, 9, 432. [Google Scholar] [CrossRef]
- Mittal, V. Synthesis Techniques for Polymer Nanocomposites; John Wiley & Sons: Hoboken, NJ, USA, 2014. [Google Scholar] [CrossRef]
- Oliveira, M.; Machado, A.V. Preparation of polymer-based nanocomposites by different routes. Nanocomposites Synth. Charact. Appl. 2013, 430, 1–22. [Google Scholar]
- Nikolaidis, A.K.; Achilias, D.S.; Karayannidis, G.P. Synthesis and characterization of PMMA/organomodified montmorillonite nanocomposites prepared by in situ bulk polymerization. Ind. Eng. Chem. Res. 2011, 50, 571–579. [Google Scholar] [CrossRef]
- Youssef, A.M.; El-Sayed, S.M. Bionanocomposites materials for food packaging applications: Concepts and future outlook. Carbohydr. Polym. 2018, 193, 19–27. [Google Scholar] [CrossRef]
- Sharma, R.; Jafari, S.M.; Sharma, S. Antimicrobial bio-nanocomposites and their potential applications in food packaging. Food Control 2020, 112, 107086. [Google Scholar] [CrossRef]
- Tsagkalias, I.S.; Loukidi, A.; Chatzimichailidou, S.; Salmas, C.E.; Giannakas, A.E.; Achilias, D.S. Effect of na- and organo-modified montmorillonite/essential oil nanohybrids on the kinetics of the in situ radical polymerization of styrene. Nanomaterials 2021, 11, 474. [Google Scholar] [CrossRef]
- Andriotis, E.G.; Papi, R.M.; Paraskevopoulou, A.; Achilias, D.S. Synthesis of d-limonene loaded polymeric nanoparticles with enhanced antimicrobial properties for potential application in food packaging. Nanomaterials 2021, 11, 191. [Google Scholar] [CrossRef] [PubMed]
- Kim, J.S.; Kuk, E.; Yu, K.N.; Kim, J.H.; Park, S.J.; Lee, H.J.; Kim, S.H.; Pary, Y.K.; Park, Y.H.; Hwang, C.-Y.; et al. Antimicrobial effects of silver nanoparticles. Nanomed. Nanotechnol. Biol. Med. 2007, 3, 95–101. [Google Scholar] [CrossRef] [PubMed]
- Rai, M.; Yadav, A.; Gade, A. Silver nanoparticles as a new generation of antimicrobials. Biotechnol. Adv. 2009, 27, 76–83. [Google Scholar] [CrossRef] [PubMed]
- Siddiqui, M.N.; Redhwi, H.H.; Tsagkalias, I.; Softas, C.; Ioannidou, M.D.; Achilias, D. Synthesis and characterization of poly(2-hydroxyethyl methacrylate)/silver hydrogel nanocomposites prepared via in situ radical polymerization. Thermochim. Acta 2016, 643, 53–64. [Google Scholar] [CrossRef]
- Poudel, M.B.; Kim, A.A. Silver nanoparticles decorated TiO2 nanoflakes for antibacterial properties. Inorg. Chem. Commun. 2023, 152, 110675. [Google Scholar] [CrossRef]
- Poudel, M.B.; Shin, M.; Kim, H.J. Polyaniline-silver-manganese dioxide nanorod ternary composite for asymmetric supercapacitor with remarkable electrochemical performance. Int. J. Hydrog. Energy 2021, 46, 474–485. [Google Scholar] [CrossRef]
- Marambio-Jones, C.; Hoek, E.M.V. A review of the antibacterial effects of silver nanomaterials and potential implications for human health and the environment. J. Nanoparticle Res. 2010, 12, 1531–1551. [Google Scholar] [CrossRef]
- González-Henríquez, C.M.; Pizarro, G.D.C.; Sarabia-Vallejos, M.A.; Terraza, C.A.; López-Cabaña, Z.E. In situ-preparation and characterization of silver-HEMA/PEGDA hydrogel matrix nanocomposites: Silver inclusion studies into hydrogel matrix. Arab. J. Chem. 2014, 12, 1413–1423. [Google Scholar] [CrossRef]
- Kassaee, M.Z.; Mohammadkhani, M.; Akhavan, A.; Mohammadi, R. In situ formation of silver nanoparticles in PMMA via reduction of silver ions by butylated hydroxytoluene. Struct. Chem. 2011, 22, 11–15. [Google Scholar] [CrossRef]
- Espitia, P.; Soares, N.D.; Coimbra, J.D.; de Andrade, N.; Cruz, R.; Medeiros, E. Zinc oxide nanoparticles: Synthesis, antimicrobial activity and food packaging applications. Food Bioprocess Technol. 2012, 5, 1447–1464. [Google Scholar] [CrossRef]
- Siddiqi, K.S.; Rahman, A.U.; Tajuddin; Husen, A. Properties of Zinc Oxide Nanoparticles and Their Activity Against Microbes. Nanoscale Res Lett. 2018, 13, 1–13. [Google Scholar] [CrossRef] [PubMed]
- Jiang, J.; Pi, J.; Cai, J. The Advancing of Zinc Oxide Nanoparticles for Biomedical Applications. Bioinorg. Chem. Appl. 2018, 2018, 1062562. [Google Scholar] [CrossRef] [PubMed]
- Duncan, T.V. Applications of nanotechnology in food packaging and food safety: Barrier materials, antimicrobials and sensors. J. Colloid Interface Sci. 2011, 363, 1–24. [Google Scholar] [CrossRef] [PubMed]
- Diaz-Visurraga, J.; Melendrez, M.F.; Garcia, A.; Paulraj, M.; Cardenas, G. Semitransparent chitosan-TiO2 nanotubes composite film for food package applications. J. Appl. Polym. Sci. 2010, 116, 3503–3515. [Google Scholar] [CrossRef]
- Xing, Y.; Li, X.; Zhang, L.; Xu, Q.; Che, Z.; Li, W.; Bai, Y.; Li, K. Effect of TiO2 nanoparticles on the antibacterial and physical properties of polyethylene-based film. Prog. Org. Coat. 2012, 73, 219. [Google Scholar] [CrossRef]
- Zou, X.P.; Kang, E.T.; Neoh, K.G. Plasma-induced graft polymerization of poly (ethylene glycol) methyl ether methacrylate on poly (tetrafluoroethylene) films for reduction in protein adsorption. Surf. Coat. Technol. 2002, 149, 119–128. [Google Scholar] [CrossRef]
- Hernández-Martínez, A.R.; Bucio, E. Radiation-induced grafting of stimuli-responsive binary monomers: PDMAEMA/PEGMEMA onto PP films. J. Radioanal. Nucl. Chem. 2010, 283, 559–563. [Google Scholar] [CrossRef]
- Boura-Theodoridou, O.; Giannakas, A.; Katapodis, P.; Stamatis, H.; Ladavos, A.; Barkoula, N.-M. Performance of ZnO/chitosan nanocomposite films for antimicrobial packaging applications as a function of NaOH treatment and glycerol/PVOH blending. Food Packag. Shelf Life 2020, 23, 100456. [Google Scholar] [CrossRef]
- Rhim, J.W.; Wang, L.F.; Hong, S.I. Preparation and characterization of agar/silver nanoparticles composite films with antimicrobial activity. Food Hydrocoll. 2013, 33, 327–335. [Google Scholar] [CrossRef]
- Pascual, A.M.; Vicente, A.L. ZnO-reinforced poly(3-hydroxybutyrate-co-3-hydroxyvalerate) bionanocomposites with antimicrobial function for food packaging. ACS Appl. Mater. Interfaces 2014, 6, 9822–9834. [Google Scholar] [CrossRef] [PubMed]

| Material | Escherichia coli | Staphylococcus aureus | Bacillus subtilis | Bacillus cereus |
|---|---|---|---|---|
| PEGMA | 341 (m) | 36 | 373 (m) | 354 (m) |
| PEGMA/AgNPs | 0 | 2 | 0 | 2 |
| PEGMA/TiO2 | 52 | 73 | 0 | 156 |
| PEGMA/ZnO | 318 (m) | 38 (m) | 56 | 296 |
| PEGMEMA | 376 (m) | 11 | 395 (m) | 382 (m) |
| PEGMEMA/AgNPs | 0 | 3 | 0 | 0 |
| PEGMEMA/TiO2 | 0 | 0 | 0 | 131 |
| PEGMEMA/ZnO | 0 | 0 | 0 | 319 |
| Material | E. coli | S. aureus | B. subtilis | B. cereus |
|---|---|---|---|---|
| PEGMA | 0 | 0 | 0 | 0 |
| PEGMA/AgNPs | 99.7 | 94.4 | 98.6 | 61.0 |
| PEGMA/TiO2 | 84.8 | 0 | 97.5 | 26.0 |
| PEGMA/ZnO | 0 | 0 | 0 | 7.5 |
| PEGMEMA | 0 | 0 | 0 | 0 |
| PEGMEMA/AgNPs | 100 | 100 | 100 | 100 |
| PEGMEMA/TiO2 | 100 | 100 | 100 | 79.8 |
| PEGMEMA/ZnO | 100 | 100 | 100 | 50.9 |
Disclaimer/Publisher’s Note: The statements, opinions and data contained in all publications are solely those of the individual author(s) and contributor(s) and not of MDPI and/or the editor(s). MDPI and/or the editor(s) disclaim responsibility for any injury to people or property resulting from any ideas, methods, instructions or products referred to in the content. |
© 2024 by the authors. Licensee MDPI, Basel, Switzerland. This article is an open access article distributed under the terms and conditions of the Creative Commons Attribution (CC BY) license (https://creativecommons.org/licenses/by/4.0/).
Share and Cite
Tsakiridou, M.; Tsagkalias, I.; Papi, R.M.; Achilias, D.S. Synthesis of Novel Nanocomposite Materials with Enhanced Antimicrobial Activity based on Poly(Ethylene Glycol Methacrylate)s with Ag, TiO2 or ZnO Nanoparticles. Nanomaterials 2024, 14, 291. https://doi.org/10.3390/nano14030291
Tsakiridou M, Tsagkalias I, Papi RM, Achilias DS. Synthesis of Novel Nanocomposite Materials with Enhanced Antimicrobial Activity based on Poly(Ethylene Glycol Methacrylate)s with Ag, TiO2 or ZnO Nanoparticles. Nanomaterials. 2024; 14(3):291. https://doi.org/10.3390/nano14030291
Chicago/Turabian StyleTsakiridou, Melpomeni, Ioannis Tsagkalias, Rigini M. Papi, and Dimitris S. Achilias. 2024. "Synthesis of Novel Nanocomposite Materials with Enhanced Antimicrobial Activity based on Poly(Ethylene Glycol Methacrylate)s with Ag, TiO2 or ZnO Nanoparticles" Nanomaterials 14, no. 3: 291. https://doi.org/10.3390/nano14030291
APA StyleTsakiridou, M., Tsagkalias, I., Papi, R. M., & Achilias, D. S. (2024). Synthesis of Novel Nanocomposite Materials with Enhanced Antimicrobial Activity based on Poly(Ethylene Glycol Methacrylate)s with Ag, TiO2 or ZnO Nanoparticles. Nanomaterials, 14(3), 291. https://doi.org/10.3390/nano14030291

